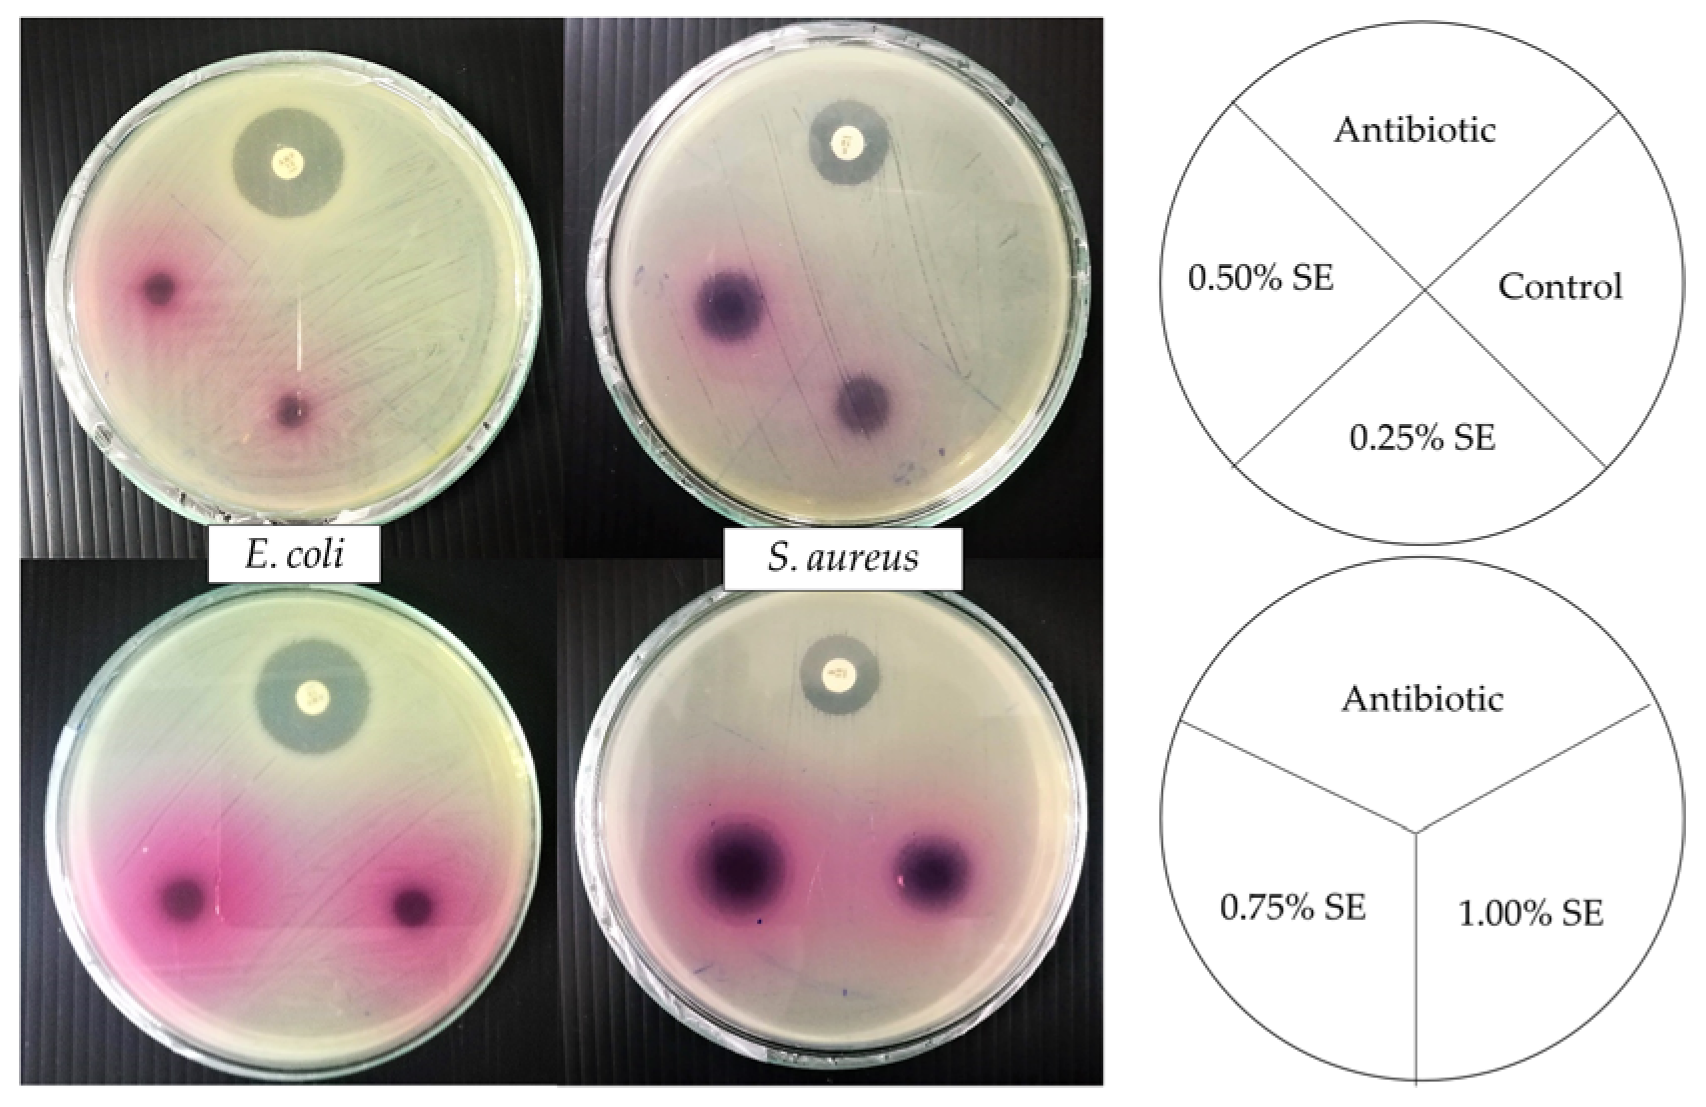
Polymers 14 02487 g003 550

Development of Intelligent Gelatin Films Incorporated with Sappan (Caesalpinia sappan L.) Heartwood Extract
Abstract
:1. Introduction
2. Materials and Methods
2.1. Materials
2.2. Preparation of Sappan Heartwood Extract
2.3. Preparation of an Intelligent Film
2.4. Characterization of Films
2.4.1. Film Thickness
2.4.2. Color Analysis of the Film
2.4.3. Light Transmission and Transparency
2.4.4. pH Sensitivity of the Film
2.4.5. Film Solubility
2.4.6. Mechanical Properties
2.4.7. Water Vapor Permeability (WVP)
2.4.8. Fourier Transform Infrared Spectroscopy (FTIR)
2.4.9. Antioxidant Activity
2.4.10. Antimicrobial Activity
2.5. Statistical Analyses
3. Results and Discussion
3.1. Film Thickness
3.2. Film Appearance and Color
3.3. Light Transmission and Transparency
3.4. pH Sensitivity of Film
3.5. Film Solubility
3.6. Mechanical Properties
3.7. Water Vapor Permeability (WVP)
3.8. FTIR
3.9. Antioxidant Properties
3.10. Antimicrobial Properties
4. Conclusions
Author Contributions
Funding
Institutional Review Board Statement
Informed Consent Statement
Data Availability Statement
Acknowledgments
Conflicts of Interest
References
- Ghaani, M.; Cozzolino, C.A.; Castelli, G.; Farris, S. An overview of the intelligent packaging technologies in the food sector. Trends Food Sci. Technol. 2016, 51, 1–11. [Google Scholar] [CrossRef] [Green Version]
- Robertson, G.L. Food Packaging: Principles and Practice; CRC press: Boca Raton, FL, USA, 2016. [Google Scholar]
- Vanderroost, M.; Ragaert, P.; Devlieghere, F.; De Meulenaer, B. Intelligent food packaging: The next generation. Trends Food Sci. Technol. 2014, 39, 47–62. [Google Scholar] [CrossRef]
- Salarbashi, D.; Tafaghodi, M.; Bazzaz, B.S.F.; Mohammad Aboutorabzade, S.; Fathi, M. pH-sensitive soluble soybean polysaccharide/SiO2 incorporated with curcumin for intelligent packaging applications. Food Sci. Nutr. 2021, 9, 2169–2179. [Google Scholar] [CrossRef] [PubMed]
- Soon, J.M.; Manning, L. Developing anti-counterfeiting measures: The role of smart packaging. Food Res. Int. 2019, 123, 135–143. [Google Scholar] [CrossRef] [PubMed]
- Musso, Y.S.; Salgado, P.R.; Mauri, A.N. Smart gelatin films prepared using red cabbage (Brassica oleracea L.) extracts as solvent. Food Hydrocoll. 2019, 89, 674–681. [Google Scholar] [CrossRef]
- Morsy, M.K.; Zór, K.; Kostesha, N.; Alstrøm, T.S.; Heiskanen, A.; El-Tanahi, H.; Sharoba, A.; Papkovsky, D.; Larsen, J.; Khalaf, H. Development and validation of a colorimetric sensor array for fish spoilage monitoring. Food Control 2016, 60, 346–352. [Google Scholar] [CrossRef]
- Bhargava, N.; Sharanagat, V.S.; Mor, R.S.; Kumar, K. Active and intelligent biodegradable packaging films using food and food waste-derived bioactive compounds: A review. Trends Food Sci. Technol. 2020, 105, 385–401. [Google Scholar] [CrossRef]
- Kurek, M.; Hlupić, L.; Ščetar, M.; Bosiljkov, T.; Galić, K. Comparison of Two pH Responsive Color Changing Bio-Based Films Containing Wasted Fruit Pomace as a Source of Colorants. J. Food Sci. 2019, 84, 2490–2498. [Google Scholar] [CrossRef]
- Alizadeh-Sani, M.; Mohammadian, E.; Rhim, J.-W.; Jafari, S.M. pH-sensitive (halochromic) smart packaging films based on natural food colorants for the monitoring of food quality. Trends Food Sci. Technol. 2020, 105, 93–144. [Google Scholar] [CrossRef]
- Kalpana, S.; Priyadarshini, S.; Leena, M.M.; Moses, J.; Anandharamakrishnan, C. Intelligent packaging: Trends and applications in food systems. Trends Food Sci. Technol. 2019, 93, 145–157. [Google Scholar] [CrossRef]
- Latos-Brozio, M.; Masek, A. The application of natural food colorants as indicator substances in intelligent biodegradable packaging materials. Food Chem. Toxicol. 2020, 135, 110975. [Google Scholar] [CrossRef] [PubMed]
- Toegel, S.; Wu, S.Q.; Otero, M.; Goldring, M.B.; Leelapornpisid, P.; Chiari, C.; Kolb, A.; Unger, F.M.; Windhager, R.; Viernstein, H. Caesalpinia sappan extract inhibits IL1β-mediated overexpression of matrix metalloproteinases in human chondrocytes. Genes Nutr. 2012, 7, 307–318. [Google Scholar] [CrossRef] [PubMed] [Green Version]
- Yun, J.; Lee, H.M.; Kim, S.K.; Lee, S.-Y.; Lee, C.S.; Cho, T.-S. Formation of Cu (II)–brazilin complex in the presence of DNA and its activities as chemical nuclease. J. Inorg. Biochem. 2006, 100, 1501–1505. [Google Scholar] [CrossRef] [PubMed]
- De Oliveira, L.F.; Edwards, H.G.; Velozo, E.S.; Nesbitt, M. Vibrational spectroscopic study of brazilin and brazilein, the main constituents of brazilwood from Brazil. Vib. Spectrosc. 2002, 28, 243–249. [Google Scholar] [CrossRef]
- Lioe, H.; Adawiyah, D.; Anggraeni, R. Isolation and characterization of the major natural dyestuff component of Brazilwood (Caesalpinia sappan L.). Int. Food Res. J. 2012, 19, 537. [Google Scholar]
- Yan, Y.; Chen, Y.-C.; Lin, Y.-H.; Guo, J.; Niu, Z.-R.; Li, L.; Wang, S.-B.; Fang, L.-H.; Du, G.-H. Brazilin isolated from the heartwood of Caesalpinia sappan L. induces endothelium-dependent and-independent relaxation of rat aortic rings. Acta Pharmacol. Sin. 2015, 36, 1318–1326. [Google Scholar] [CrossRef]
- Manhita, A.; Santos, V.; Vargas, H.; Candeias, A.; Ferreira, T.; Dias, C.B. Ageing of brazilwood dye in wool—A chromatographic and spectrometric study. J. Cult. Herit. 2013, 14, 471–479. [Google Scholar] [CrossRef]
- Sasaki, Y.; Hosokawa, T.; Nagai, M.; Nagumo, S. In vitro study for inhibition of NO production about constituents of Sappan Lignum. Biol. Pharm. Bull. 2007, 30, 193–196. [Google Scholar] [CrossRef] [Green Version]
- Xu, H.X.; Lee, S.F. The antibacterial principle of Caesalpina sappan. Phytother. Res. Int. J. Devoted Pharmacol. Toxicol. Eval. Nat. Prod. Deriv. 2004, 18, 647–651. [Google Scholar]
- Yodsaoue, O.; Cheenpracha, S.; Karalai, C.; Ponglimanont, C.; Tewtrakul, S. Anti-allergic activity of principles from the roots and heartwood of caesalpinia sappan on antigen-induced β-hexosaminidase release. Phytother. Res. Int. J. Devoted Pharmacol. Toxicol. Eval. Nat. Prod. Deriv. 2009, 23, 1028–1031. [Google Scholar] [CrossRef]
- Kowalczyk, D.; Baraniak, B. Effects of plasticizers, pH and heating of film-forming solution on the properties of pea protein isolate films. J. Food Eng. 2011, 105, 295–305. [Google Scholar] [CrossRef]
- Zhao, G.; Lyu, X.; Lee, J.; Cui, X.; Chen, W.-N. Biodegradable and transparent cellulose film prepared eco-friendly from durian rind for packaging application. Food Packag. Shelf Life 2019, 21, 100345. [Google Scholar] [CrossRef]
- Zahan, K.A.; Azizul, N.M.; Mustapha, M.; Tong, W.Y.; Rahman, M.S.A. Application of bacterial cellulose film as a biodegradable and antimicrobial packaging material. Mater. Today Proc. 2020, 31, 83–88. [Google Scholar] [CrossRef]
- Rawdkuen, S.; Suthiluk, P.; Kamhangwong, D.; Benjakul, S. Mechanical, physico-chemical, and antimicrobial properties of gelatin-based film incorporated with catechin-lysozyme. Chem. Cent. J. 2012, 6, 131. [Google Scholar] [CrossRef] [Green Version]
- Pereira, V.A., Jr.; de Arruda, I.N.Q.; Stefani, R. Active chitosan/PVA films with anthocyanins from Brassica oleraceae (Red Cabbage) as Time–Temperature Indicators for application in intelligent food packaging. Food Hydrocoll. 2015, 43, 180–188. [Google Scholar] [CrossRef]
- Kaewprachu, P.; Osako, K.; Benjakul, S.; Tongdeesoontorn, W.; Rawdkuen, S. Biodegradable protein-based films and their properties: A comparative study. Packag. Technol. Sci. 2016, 29, 77–90. [Google Scholar] [CrossRef]
- Rao, M.; Kanatt, S.; Chawla, S.; Sharma, A. Chitosan and guar gum composite films: Preparation, physical, mechanical and antimicrobial properties. Carbohydr. Polym. 2010, 82, 1243–1247. [Google Scholar] [CrossRef]
- Choi, I.; Lee, J.Y.; Lacroix, M.; Han, J. Intelligent pH indicator film composed of agar/potato starch and anthocyanin extracts from purple sweet potato. Food Chem. 2017, 218, 122–128. [Google Scholar] [CrossRef]
- Jongjareonrak, A.; Benjakul, S.; Visessanguan, W.; Tanaka, M. Effects of plasticizers on the properties of edible films from skin gelatin of bigeye snapper and brownstripe red snapper. Eur. Food Res. Technol. 2006, 222, 229–235. [Google Scholar] [CrossRef]
- Gennadios, A.; Handa, A.; Froning, G.W.; Weller, C.L.; Hanna, M.A. Physical properties of egg white− dialdehyde starch films. J. Agric. Food Chem. 1998, 46, 1297–1302. [Google Scholar] [CrossRef]
- ASTM D882-02; Standard Test Method for Tensile Properties of Thin Plastic Sheeting. ASTM International: West Conshohocken, PA, USA, 2002.
- ASTM E96/E96M-22; Standard Test Methods for Gravimetric Determination of Water Vapor Transmission Rate of Materials. ASTM International: West Conshohocken, PA, USA, 1989.
- McHugh, T.H.; Avena-Bustillos, R.; Krochta, J. Hydrophilic edible films: Modified procedure for water vapor permeability and explanation of thickness effects. J. Food Sci. 1993, 58, 899–903. [Google Scholar] [CrossRef]
- Pereira de Abreu, D.; Cruz, J.M.; Paseiro Losada, P. Active and intelligent packaging for the food industry. Food Rev. Int. 2012, 28, 146–187. [Google Scholar] [CrossRef]
- Tongnuanchan, P.; Benjakul, S.; Prodpran, T. Properties and antioxidant activity of fish skin gelatin film incorporated with citrus essential oils. Food Chem. 2012, 134, 1571–1579. [Google Scholar] [CrossRef] [PubMed]
- Canillac, N.; Mourey, A. Antibacterial activity of the essential oil of Picea excelsa on Listeria, Staphylococcus aureus and coliform bacteria. Food Microbiol. 2001, 18, 261–268. [Google Scholar] [CrossRef]
- Hanani, Z.N.; Yee, F.C.; Nor-Khaizura, M. Effect of pomegranate (Punica granatum L.) peel powder on the antioxidant and antimicrobial properties of fish gelatin films as active packaging. Food Hydrocoll. 2019, 89, 253–259. [Google Scholar] [CrossRef]
- Zhang, X.; Ma, L.; Yu, Y.; Zhou, H.; Guo, T.; Dai, H.; Zhang, Y. Physico-mechanical and antioxidant properties of gelatin film from rabbit skin incorporated with rosemary acid. Food Packag. Shelf Life 2019, 19, 121–130. [Google Scholar] [CrossRef]
- Nirmal, N.P.; Rajput, M.S.; Prasad, R.G.; Ahmad, M. Brazilin from Caesalpinia sappan heartwood and its pharmacological activities: A review. Asian Pac. J. Trop. Med. 2015, 8, 421–430. [Google Scholar] [CrossRef] [Green Version]
- Tymczewska, A.; Furtado, B.U.; Nowaczyk, J.; Hrynkiewicz, K.; Szydłowska-Czerniak, A. Development and Characterization of Active Gelatin Films Loaded with Rapeseed Meal Extracts. Materials 2021, 14, 2869. [Google Scholar] [CrossRef]
- Monedero, F.M.; Fabra, M.J.; Talens, P.; Chiralt, A. Effect of oleic acid–beeswax mixtures on mechanical, optical and water barrier properties of soy protein isolate based films. J. Food Eng. 2009, 91, 509–515. [Google Scholar] [CrossRef]
- Wang, X.; Yong, H.; Gao, L.; Li, L.; Jin, M.; Liu, J. Preparation and characterization of antioxidant and pH-sensitive films based on chitosan and black soybean seed coat extract. Food Hydrocoll. 2019, 89, 56–66. [Google Scholar] [CrossRef]
- Liu, J.; Yong, H.; Liu, Y.; Qin, Y.; Kan, J.; Liu, J. Preparation and characterization of active and intelligent films based on fish gelatin and haskap berries (Lonicera caerulea L.) extract. Food Packag. Shelf Life 2019, 22, 100417. [Google Scholar] [CrossRef]
- Peralta, J.; Bitencourt-Cervi, C.M.; Maciel, V.B.; Yoshida, C.M.; Carvalho, R.A. Aqueous hibiscus extract as a potential natural pH indicator incorporated in natural polymeric films. Food Packag. Shelf Life 2019, 19, 47–55. [Google Scholar] [CrossRef]
- Zhang, W.; Li, X.; Jiang, W. Development of antioxidant chitosan film with banana peels extract and its application as coating in maintaining the storage quality of apple. Int. J. Biol. Macromol. 2020, 154, 1205–1214. [Google Scholar] [CrossRef] [PubMed]
- Kaewprachu, P.; Rungraeng, N.; Osako, K.; Rawdkuen, S. Properties of fish myofibrillar protein film incorporated with catechin-Kradon extract. Food Packag. Shelf Life 2017, 13, 56–65. [Google Scholar] [CrossRef]
- Roy, S.; Rhim, J.-W. Preparation of antimicrobial and antioxidant gelatin/curcumin composite films for active food packaging application. Colloids Surf. B Biointerfaces 2020, 188, 110761. [Google Scholar] [CrossRef] [PubMed]
- Adams, M.R.; Moss, M.O.; Moss, M.O. Food Microbiology; Royal Society of Chemistry: London, UK, 2000. [Google Scholar]
- Rahayuningsih, E.; Budhijanto, W.; Prasasti, H.F.; Wahyuningrum, M.T. Chemical Modifications for Intensity Variation and Spectrum Extension of Brazilein Extract from Sappanwood (Caesalpinia sappan L.). MATEC Web Conf. 2018, 156, 01020. [Google Scholar] [CrossRef] [Green Version]
- Fatoni, A.; Anggraeni, M.D.; Zulhidayah, L.Z. Natural reagent from Secang (Caesalpinia sappan L.) heartwood for urea biosensor. IOP Conf. Ser. Mater. Sci. Eng 2019, 509, 012010. [Google Scholar]
- Wang, S.; Marcone, M.; Barbut, S.; Lim, L.T. The impact of anthocyanin-rich red raspberry extract (ARRE) on the properties of edible soy protein isolate (SPI) films. J. Food Sci. 2012, 77, C497–C505. [Google Scholar] [CrossRef]
- Hanani, Z.N.; Husna, A.A.; Syahida, S.N.; Khaizura, M.N.; Jamilah, B. Effect of different fruit peels on the functional properties of gelatin/polyethylene bilayer films for active packaging. Food Packag. Shelf Life 2018, 18, 201–211. [Google Scholar] [CrossRef]
- Rivero, S.; García, M.; Pinotti, A. Crosslinking capacity of tannic acid in plasticized chitosan films. Carbohydr. Polym. 2010, 82, 270–276. [Google Scholar] [CrossRef]
- Mir, S.A.; Dar, B.; Wani, A.A.; Shah, M.A. Effect of plant extracts on the techno-functional properties of biodegradable packaging films. Trends Food Sci. Technol. 2018, 80, 141–154. [Google Scholar] [CrossRef]
- Kadam, D.; Shah, N.; Palamthodi, S.; Lele, S. An investigation on the effect of polyphenolic extracts of Nigella sativa seedcake on physicochemical properties of chitosan-based films. Carbohydr. Polym. 2018, 192, 347–355. [Google Scholar] [CrossRef] [PubMed]
- Kadam, D.; Lele, S. Cross-linking effect of polyphenolic extracts of Lepidium sativum seedcake on physicochemical properties of chitosan films. Int. J. Biol. Macromol. 2018, 114, 1240–1247. [Google Scholar] [CrossRef] [PubMed]
- Suderman, N.; Sarbon, N. Preparation and characterization of gelatin-based films with the incorporation of Centella asiatica (L.) urban extract. Food Res. 2019, 3, 506–514. [Google Scholar] [CrossRef]
- Bravin, F.M.; Busnelli, G.; Colombo, M.; Gatti, F.; Manzoni, L.; Scolastico, C. Synthesis of conformationally restricted and optically pure analogues of serine-proline dipeptide via aldol condensation. Synthesis 2004, 2004, 353–358. [Google Scholar]
- Lee, M.H.; Kim, S.Y.; Park, H.J. Effect of halloysite nanoclay on the physical, mechanical, and antioxidant properties of chitosan films incorporated with clove essential oil. Food Hydrocoll. 2018, 84, 58–67. [Google Scholar] [CrossRef]
- Rasid, N.; Nazmi, N.; Isa, M.; Sarbon, N. Rheological, functional and antioxidant properties of films forming solution and active gelatin films incorporated with Centella asiatica (L.) urban extract. Food Packag. Shelf Life 2018, 18, 115–124. [Google Scholar] [CrossRef]
- Zhai, X.; Li, Z.; Zhang, J.; Shi, J.; Zou, X.; Huang, X.; Zhang, D.; Sun, Y.; Yang, Z.; Holmes, M. Natural biomaterial-based edible and pH-sensitive films combined with electrochemical writing for intelligent food packaging. J. Agric. Food Chem. 2018, 66, 12836–12846. [Google Scholar] [CrossRef]
- Bergo, P.; Sobral, P. Effects of plasticizer on physical properties of pigskin gelatin films. Food Hydrocoll. 2007, 21, 1285–1289. [Google Scholar] [CrossRef]
- Kaya, M.; Khadem, S.; Cakmak, Y.S.; Mujtaba, M.; Ilk, S.; Akyuz, L.; Salaberria, A.M.; Labidi, J.; Abdulqadir, A.H.; Deligöz, E. Antioxidative and antimicrobial edible chitosan films blended with stem, leaf and seed extracts of Pistacia terebinthus for active food packaging. RSC Adv. 2018, 8, 3941–3950. [Google Scholar] [CrossRef] [Green Version]
- Siripatrawan, U.; Harte, B.R. Physical properties and antioxidant activity of an active film from chitosan incorporated with green tea extract. Food Hydrocoll. 2010, 24, 770–775. [Google Scholar] [CrossRef]
- Giménez, B.; Alemán, A.; Montero, P.; Gómez-Guillén, M. Antioxidant and functional properties of gelatin hydrolysates obtained from skin of sole and squid. Food Chem. 2009, 114, 976–983. [Google Scholar] [CrossRef] [Green Version]
- Wei, Y.-C.; Cheng, C.-H.; Ho, Y.-C.; Tsai, M.-L.; Mi, F.-L. Active gellan gum/purple sweet potato composite films capable of monitoring pH variations. Food Hydrocoll. 2017, 69, 491–502. [Google Scholar] [CrossRef]
- Srinivasan, R.; Selvam, G.G.; Karthik, S.; Mathivanan, K.; Baskaran, R.; Karthikeyan, M.; Gopi, M.; Govindasamy, C. In vitro antimicrobial activity of Caesalpinia sappan L. Asian Pac. J. Trop. Biomed. 2012, 2, S136–S139. [Google Scholar] [CrossRef]

| SE (%, w/v) | Thickness (mm) | Film Solubility (%) | WVP (×10−11 g m/m2 s Pa) | TS (MPa) | EAB (%) |
|---|---|---|---|---|---|
| 0 | 0.043 ± 0.001 e | 43.88 ± 1.20 a | 9.09 ± 0.72 a | 9.35 ± 0.74 a | 77.98 ± 6.95 a |
| 0.25 | 0.050 ± 0.002 d | 35.99 ± 2.83 b | 8.12 ± 0.23 b | 8.97 ± 0.59 a | 77.67 ± 7.11 a |
| 0.50 | 0.054 ± 0.002 c | 32.66 ± 1.56 bc | 7.74 ± 0.22 b | 8.91 ± 0.74 a | 70.21 ± 5.55 b |
| 0.75 | 0.058 ± 0.001 b | 32.07 ± 2.20 cd | 6.78 ± 0.40 c | 8.73 ± 0.89 a | 62.69 ± 3.93 c |
| 1.00 | 0.063 ± 0.001 a | 28.93 ± 1.37 d | 6.48 ± 0.21 c | 7.61 ± 0.74 b | 62.73 ± 3.70 c |
| SE (%, w/v) | Color | |||
|---|---|---|---|---|
| L* | a* | b* | ||
| 0 |  | 85.37 ± 0.42 a | 3.33 ± 0.12 d | −4.20 ± 0.10 e |
| 0.25 |  | 66.87 ± 1.32 b | 22.43 ± 1.75 c | 38.87 ± 1.65 d |
| 0.50 |  | 60.53 ± 1.59 c | 33.40 ± 2.46 b | 49.67 ± 1.06 a |
| 0.75 |  | 51.27 ± 2.22 d | 47.13 ± 1.54 a | 46.50 ± 0.78 b |
| 1.00 |  | 50.17 ± 0.78 d | 48.67 ± 1.06 a | 43.40 ± 1.49 c |
| SE (%, w/v) | Wavelength (nm) | Transparency * | |||||||
|---|---|---|---|---|---|---|---|---|---|
| 200 | 280 | 350 | 400 | 500 | 600 | 700 | 800 | ||
| 0 | 0.09 a | 36.02 a | 69.49 a | 76.61 a | 82.07 a | 84.24 a | 85.40 a | 86.13 a | 3.30 ± 0.01 a |
| 0.25 | 0.03 b | 0.02 b | 16.78 b | 30.98 b | 48.31 b | 81.15 ab | 86.80 a | 87.69 a | 3.21 ± 0.01 b |
| 0.50 | 0.02 c | 0.01b | 4.18 c | 11.79 c | 27.06 c | 78.93 b | 87.45 a | 88.70 ab | 3.16 ± 0.01 c |
| 0.75 | 0.01 d | 0.01 b | 1.06 d | 4.24 d | 13.31 d | 71.47 c | 81.68 b | 83.71 bc | 3.09 ± 0.01 d |
| 1.00 | 0.01 d | 0.01 b | 0.22 d | 1.28 e | 5.04 e | 66.09 d | 79.43 b | 81.87 c | 3.02 ± 0.03 e |
| SE (%, w/v) | Antioxidant Activity | Antimicrobial Activity | |||
|---|---|---|---|---|---|
| TPC (mg GAE/g d.b.) | FRAP (mM Fe (II)/g d.b.) | DPPH (µM Trolox/g d.b.) | Inhibition Zone (mm) | ||
| E. coli | S. aureus | ||||
| SE | 951.62 ± 6.47 a | 3670.45 ± 13.13 a | 17,024.36 ± 135.42 a | 9.07 ± 0.38 | 22.44 ± 1.58 |
| 0 | 0.00 ± 0.00 e | 0.36 ± 0.02 f | 0.00 ± 0.00 e | ND | ND |
| 0.25 | 3.30 ± 0.18 d | 88.01 ± 4.78 e | 106.86 ± 10.73 d | ND | 10.33 ± 0.58 d |
| 0.50 | 7.84 ± 0.33 c | 150.36 ± 3.99 d | 489.99 ± 24.31 c | ND | 12.33 ± 0.58 c |
| 0.75 | 8.71 ± 0.20 c | 270.69 ± 5.18 c | 556.51 ± 21.75 c | ND | 16.00 ± 1.00 b |
| 1.00 | 15.60 ± 0.20 b | 329.84 ± 3.76 b | 782.71 ± 18.03 b | ND | 20.33 ± 2.08 a |
Publisher’s Note: MDPI stays neutral with regard to jurisdictional claims in published maps and institutional affiliations. |
© 2022 by the authors. Licensee MDPI, Basel, Switzerland. This article is an open access article distributed under the terms and conditions of the Creative Commons Attribution (CC BY) license (https://creativecommons.org/licenses/by/4.0/).
Share and Cite
Romruen, O.; Kaewprachu, P.; Karbowiak, T.; Rawdkuen, S. Development of Intelligent Gelatin Films Incorporated with Sappan (Caesalpinia sappan L.) Heartwood Extract. Polymers 2022, 14, 2487. https://doi.org/10.3390/polym14122487
Romruen O, Kaewprachu P, Karbowiak T, Rawdkuen S. Development of Intelligent Gelatin Films Incorporated with Sappan (Caesalpinia sappan L.) Heartwood Extract. Polymers. 2022; 14(12):2487. https://doi.org/10.3390/polym14122487
Chicago/Turabian StyleRomruen, Orapan, Pimonpan Kaewprachu, Thomas Karbowiak, and Saroat Rawdkuen. 2022. "Development of Intelligent Gelatin Films Incorporated with Sappan (Caesalpinia sappan L.) Heartwood Extract" Polymers 14, no. 12: 2487. https://doi.org/10.3390/polym14122487
APA StyleRomruen, O., Kaewprachu, P., Karbowiak, T., & Rawdkuen, S. (2022). Development of Intelligent Gelatin Films Incorporated with Sappan (Caesalpinia sappan L.) Heartwood Extract. Polymers, 14(12), 2487. https://doi.org/10.3390/polym14122487







